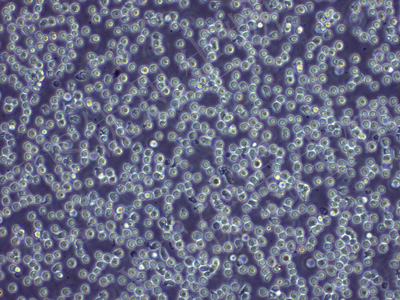
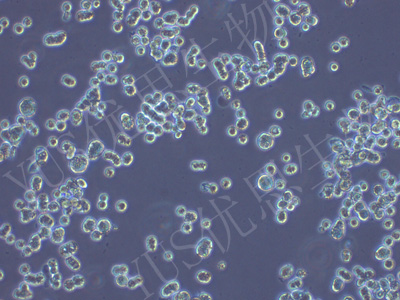
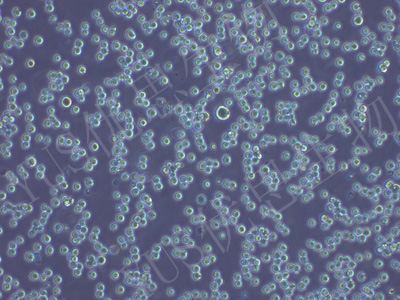

产品中心
产品中心
-
BV-173 人白血病细胞(STR鉴定)
货号:YLH678规格: 1*10^6 -

A101D 人黑色素瘤细胞(STR鉴定)
货号:YLH679规格: 1*10^6 -

SSP-25 人肝胆管癌细胞(STR鉴定)
货号:YLH680规格: 1*10^6 -

SVG p12 人脑星形胶质细胞(STR鉴定)
货号:YLH681规格: 1*10^6 -

MT-4 人急性淋巴母细胞白血病细胞(STR鉴定)
货号:YLH029规格: 1*10^6 -
COLO 320 HSR 人结直肠腺癌细胞(STR鉴定)
货号:YLH033规格: 1*10^6 -

MV-4-11 人髓性单核细胞白血病细胞(STR鉴定)
货号:YLH034规格: 1*10^6 -

HepG2.2.15 人肝癌(HBV)(STR鉴定)
货号:YLH075规格: 1*10^6 -
KG-1 人急性骨髓性白血病细胞(STR鉴定)
货号:YLH082规格: 1*10^6 -

HaCat 人永生化表皮细胞(STR鉴定)
货号:YLH130规格: 1*10^6 -

MKN-28 人胃癌细胞(STR鉴定)
货号:YLH133规格: 1*10^6 -

MUM2B 人侵袭性脉络膜黑色素瘤细胞(STR鉴定)
货号:YLH152规格: 1*10^6
在线咨询
Online consultation

关注微信公众号


